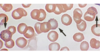

Exam 2 Spring Flashcards
(308 cards)
neoplasm
new growth: disorder of cell growth triggered by series of mutations affecting a single cell and its clonal progeny
“tumor”
“neoplasia”
all tumors have what basic cmpts?
parenchyma
- primary basis of classification of tumors and their bio behavior
reactive stroma - CT, bv, cells of immune sys
- what growth and spread of tumors depend on
demsoplasia
when parenchymal cells stim formation of abundant collagenous stroma
- some can be stony hard (scirrhous) - female breast ca
benign tumors
gross and microscopic = localized, no spread, can be excised via local sx
naming of benign tumor
name of cell origin + “-oma”
naming for epithelial tumors more complex
- cell of origin
- microscopic pattern
- macroscopic architecture
adenoma
derived from glands
but MAY OR MAY NOT form glandular structures
- like renal tubule cells - hterogenous mass of adrenal cortical cells growing as solid sheet
papillomas
beningn epith neoplasm
fingerlike, warty projections
cystadenomas
form LARGE cystic masses
ex: ovary
papillary cystadenoma
pap projections INTO cystic spaces
polyp
neoplasm (benign or malignant) projfects above mucus surf into lumen
if polyp has glandular tissue = adenomatous polyp
colon polyp
goes ABOVE mucus surf and into colon lumen
malignant tumors
ca - can invade and desroy adjacent structures and spread to met
naming malignant tumors
solid mesenchymal masses = sarcoma
blood-forming cells = leukemia
ectoderm dericed epidermis, mesoderm derived renal tubes, endoderm dervied lining of GIT = carcinomas
- can be furthur classified by their tissue of origin before the carcinoma name
mixed tumor
occurs during divergent differentiation of a single clone
ex:
- salivary gland: epithe cmpts with stroma of cartilage or bone = pleomorphic adenoma
great majority of neoplasms are composed of cells from…
a single germ layer
exception = teratoma
teratoma
recog mature/immature cells/tissues to more than 1 germ layer
- origin from totipotent norm present in ovary and testis
- sometimes found in abnormal midline emb rests
ex: dermoid cyst (ovarian cystic teratoma)
* differn prim along ectoderm lines = cystic tumor lined by skin with hair, sebaceous glands, and tooth structures
mixed tumor of the parotid gland
- epith + cartilage stroma
hamartomas
disorg benign masses of cells indigeous to involved site
choristoma
heterotpic rest of cells
- ex: well-dev & normal panc tissue found in submucosa of stom/duod/sml intestine
differentiation
exntent which neoplastic parenc cells resemble correstponding normal parenc cells: morph & fx
anaplasia
LACK of differentiation
in general, benign tumors are _________
well-diffen
only growth of these cells into a dis crete mass reveals its neoplastic nature
compare and contrast these…
leiomyoma or uterus
- well-differn tumor of bundles of smooth M cells that are VIRTUALLY identical to normal smooth M cells
adenocar of colon
- ca gland cells are irregular in shape and size and DO NOT resemble normal colon glands (top = normal, bottom = ca)
- differentiation b/c gland formation is seen
- invaded M layer of color